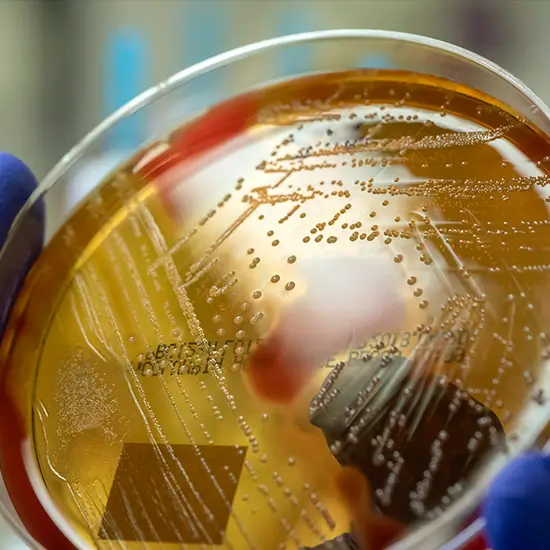

Book Culture Group B Streptococcus Appointment Online Near me at the best price in Delhi/NCR from Ganesh Diagnostic. NABL & NABH Accredited Diagnostic centre and Pathology lab in Delhi offering a wide range of Radiology & Pathology tests. Get Free Ambulance & Free Home Sample collection. 24X7 Hour Open. Call Now at 011-47-444-444 to Book your Culture Group B Streptococcus at 50% Discount.
Streptococcus is a very common bacteria that is present in intestines and lower genital tract. This bacteria is pretty harmless in healthy adults but it can be the cause of a serious illness called group B strep disease in newly born infants as their immunity is not that strong. Group B strep can be reason of life-threatening infections in adults who are already being diagnosed for diabetes and liver diseases.
Pregnant women are advised to go through Culture Group B Streptococcus test in their third trimester so that if the infection is detected then antibiotics can be taken for a healthy and complication free labour.
If you are going through following symptoms
The cost of Culture Group B Streptococcus test can be from INR 1200 to INR 1800.
Ganesh Diagnostic is one of the most leading names in pathology. We are trusted by our patients and it is their support and trust in our ability that we are thriving. Our labs contain all the latest machine that are useful for highly accurate results. We make sure that you will have a very secure and comfortable experience at a price that is affordable to all.
| Test Type | Culture Group B Streptococcus |
| Includes | Culture Group B Streptococcus Test (Hematology) |
| Preparation | |
| Reporting | Within 24 hours* |
| Test Price |
₹ 682
|

The group B strep culture becomes the new recommended timing for your screening helps which gives the 5-week window for valid culture with your results which further include the births up to gestational age of at least known for 41 0/7 weeks.
The GBS bacteria are also most commonly known to be bacteremia, with your sepsis, with pneumonia, and the meningitis in newborns. It is known to be uncommon for the GBS bacteria to further cause meningitis in your adults. Some of these infections are also invasive in nature. The Invasive disease also means that the germs that invades your parts of the body that are normally free from germs.
The people that develop your group B strep infection that helps in developing your sepsis. The Sepsis, also known as the blood poisoning. This is your body's life-threatening response to any of the infections.
The Bacteria which is called the group B Streptococcus (group B strep, GBS) can cause your GBS disease. The GBS bacteria that is commonly that a life in people’s gastrointestinal and the genital tracts. The gastrointestinal tract further becomes part of a body which digests your food and this includes stomach and even intestines.
The Doctors along with the midwives could give your antibiotic by the IV (through the vein). Most commonly it is prescribed to be a type of the antibiotic called beta-lactams, inclusive of penicillin and ampicillin. However, the antibiotics given to the women who are either severely allergic to the antibiotics.
In about 1 in every 4 pregnant women who carries the GBS bacteria in one’s body. The Doctors and the midwives should also test pregnant women for your GBS bacteria when they are already 36 through 37 weeks pregnant.
It should be noted that It may never make you sick. GBS in the adults usually doesn't have any symptoms, but it could cause some minor infections, like either bladder or the urinary tract infection (UTI). While, the GBS infection may not be as harmful to you, it can turn out be very harmful for your baby. If an individual is pregnant, you could pass it to the baby during your labor and childbirth.
You could get yourself tested for group B strep culture at the Ganesh Diagnostic and Imaging Center. We would be happy to assist you in getting your sample by trained staff and technicians.
Yes, a free doctor’s consultation is available for all individuals. Either before the test, or after the test, you can avail this facility at our center, online or in person.
Yes, everybody is eligible for getting group B strep culture from the convenient of your home. Our trained staff members and phlebotomists would get your sample collected with ease at the earliest.
Early check ups are always better than delayed ones. Safety, precaution & care is depicted from the several health checkups. Here, we present simple & comprehensive health packages for any kind of testing to ensure the early prescribed treatment to safeguard your health.